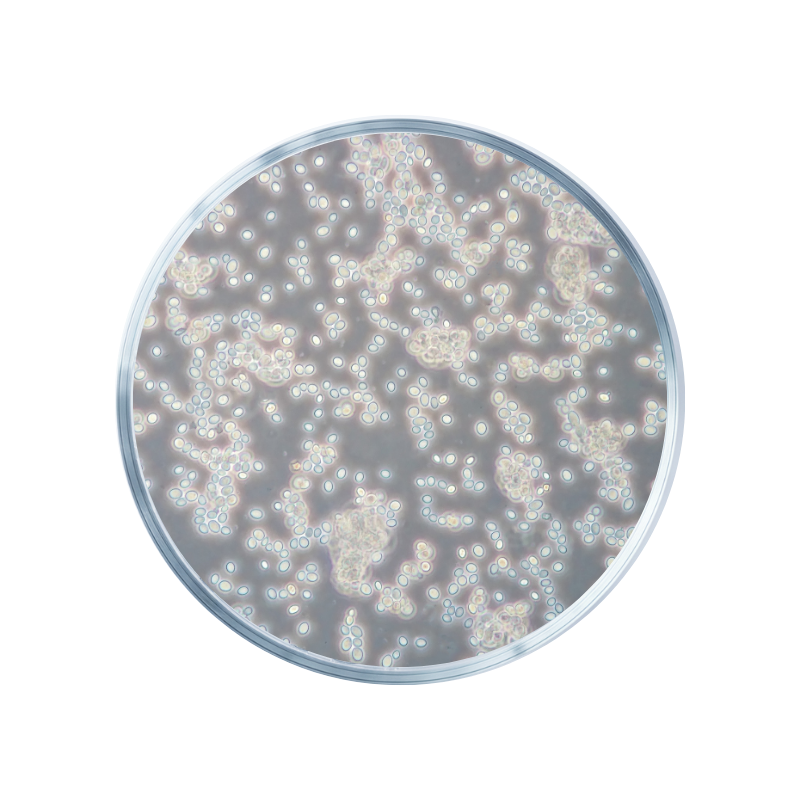

White Mulberry (Morus Alba)

Your cart
Your cart is empty
Continue shoppingDELIVERED IN 1 TO 3 WORKING DAYS
Free
delivery
ONLY €45,00 LEFT TO UNLOCK FREE DELIVERY
Order summary

Order special instructions
REE promotion: Buy 30 MB REE shots & get 15 free (worth €75)
Free EU delivery
Payment in 3 times
Subscribe to our newsletter and get a 10% discount. Click here and subscribe >
Trusted by over 100,000 customers.
Need personal advice? Contact us.
Are you in the right place? Please select your delivery country and language before placing your order.
The white mulberry (Morus alba) is a fast-growing tree with sweet, blackberry-like fruits. The berries contain vitamin C, vitamin K, potassium and iron. White mulberry can contribute to a balanced carbohydrate metabolism and supports normal glucose metabolism.
The white mulberry is a fast-growing tree that produces blackberry-like fruits. It thrives in a variety of climates and soils, which is why it can be found all over the world. The sweet fruits are beloved, while the leaves have a traditional role, for example in silkworm breeding.
These berries are rich in important vitamins such as vitamin C and vitamin K. The white mulberry also contains the valuable minerals potassium and iron.
White mulberry can help maintain the balance of carbohydrate metabolism in the body.*
The plant contains certain elements that can help support carbohydrate metabolism.
White mulberry supports normal glucose metabolism / helps maintain normal blood sugar levels.*
The white mulberry is valued for its ability to help maintain stable blood sugar levels, making it a popular choice among people looking to balance their glucose levels.
Yes, Insentials GLH-2 contains white mulberry extract.
*Health claims pending European approval